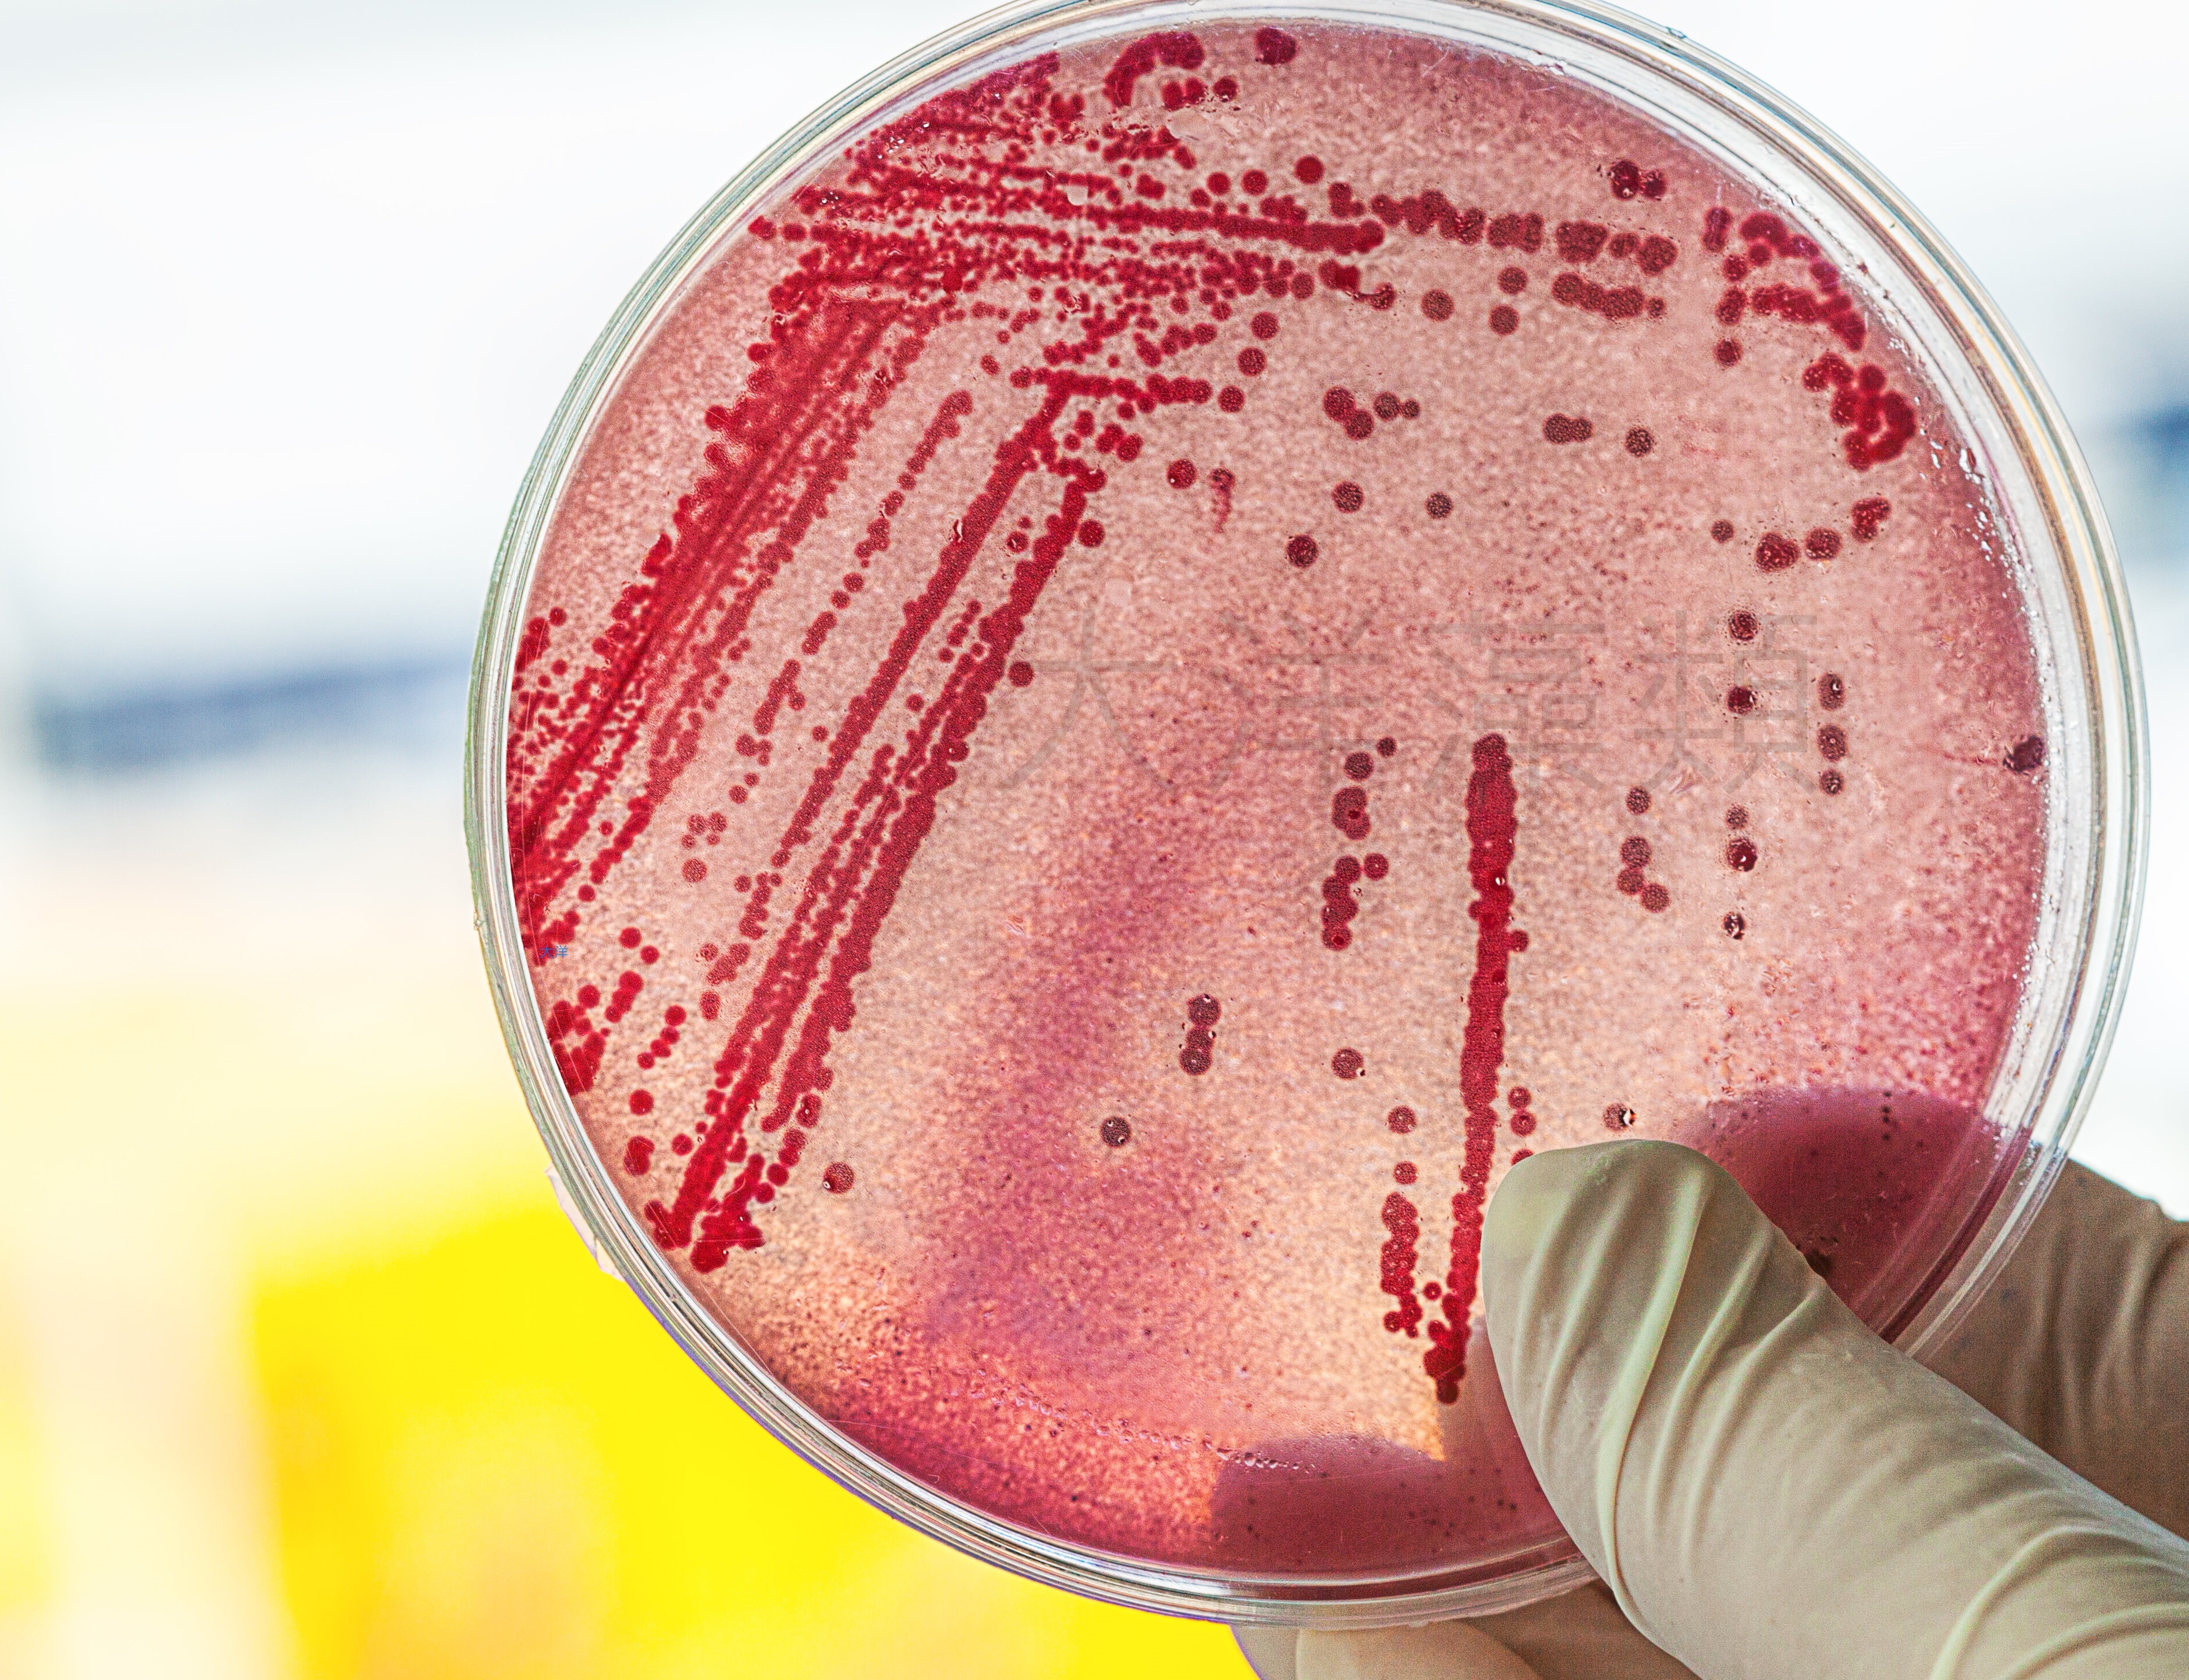

{{ 'fb_in_app_browser_popup.desc' | translate }} {{ 'fb_in_app_browser_popup.copy_link' | translate }}
{{ 'in_app_browser_popup.desc' | translate }}
{{word('consent_desc')}} {{word('read_more')}}
{{setting.description}}
{{ childProduct.title_translations | translateModel }}
{{ getChildVariationShorthand(childProduct.child_variation) }}
{{ getSelectedItemDetail(selectedChildProduct, item).childProductName }} x {{ selectedChildProduct.quantity || 1 }}
{{ getSelectedItemDetail(selectedChildProduct, item).childVariationName }}
分類
商品存貨不足,未能加入購物車
您所填寫的商品數量超過庫存
{{'products.quick_cart.out_of_number_hint'| translate}}
{{'product.preorder_limit.hint'| translate}}
每筆訂單限購 {{ product.max_order_quantity }} 件
現庫存只剩下 {{ quantityOfStock }} 件

超商取貨單筆最多4.5公升,超過或同時訂購其他商品,請改需用宅配方式。
菌種培養成功率較活菌大,如果只是要拿來用,且長期使用,建議可購買活菌即可。
=======================================================
■ 減輕硝化菌的負擔,幫助硝化菌成長健全
■ 消除缸底、池底的惡臭
■ 調控PH,預防水質酸化
■ 改善老缸症候群
■ 改善水質飼養密度高,餵食較多,造成的水質惡化,
■ 提升魚隻免疫,長期使用可以感受到魚兒的穩定
■ 菌種來源:水試所
=======================================================
■水族建議用法:總水體量1噸以內
1. 每10公升水量,初次使用10cc,之後每次約使用3cc,每週1-3次。用量及頻率,可依水質狀況做調整。光合菌超量使用,很安全,無危險的顧慮。
2. 為避免感染,請用「倒出」的方式使用,再用吸管餵食。避免吸管進入瓶內,造成感染。
=======================================================
■池塘、水池建議用法:總水體量100噸以內
每1噸水,初次使用0.5公升,之後每次使用0.3公升,每週1-3次。用量及頻率,可依水質狀況做調整。光合菌超量使用,很安全,無危險的顧慮。
=======================================================
■水產養殖:以分或甲計算
每1甲地,每週使用60-100公升。用量及頻率,可依水質狀況做調整。
=======================================================
■保存方式:
1. 密閉封口、提供光照、室溫保存、每日搖晃。避免陽光直射或完全無陽光,在無感染下,可保存半年。
2. 光線較少情況下,有時保存會有白色薄膜產生,屬正常現象。
3. 因菌數高,保存時會陸續沉澱,使用前請搖晃均勻後再使用。
=======================================================
■注意事項:
1. 本公司光合菌並不會與其他菌種衝突,請安心使用。
2. 正在養水開缸者,請勿放光合菌。
3. 添加本公司光合菌,無須關閉過濾和蛋白。
4. 有下藥治療者,可以停止使用,待水中藥效退了大部分後,再恢復使用即可,此時會建議增量使用,以免水質惡化。
5. UV殺菌燈、奈米銀,經實測,對光合菌影響有限。
6. 超量使用:經實測,10公升水體,一次添加到0.3公升,連續幾週添加,對魚隻和珊瑚,完全無害。
=======================================================
■農用:
農用/植物用光合菌用量:
葉面噴灑請稀釋800-1000倍,土壤澆灌請稀釋500-800倍。